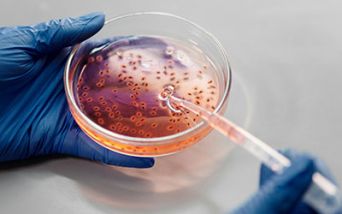
Nuovo allarme colera

Copertura vaccinale insufficiente e criticità sanitarie: l’Europa non è immune al ritorno delle malattie trascurate
Per decenni sembrava una malattia confinata nei libri di storia o ai resoconti dei Paesi più poveri e invece il colera è tornato a far parlare di sé, conquistando titoli e prime pagine. L’Organizzazione Mondiale della Sanità (OMS) ha lanciato un nuovo allarme: nel 2024 i casi segnalati sono aumentati del 5% rispetto all’anno precedente, mentre i decessi hanno subito un’impennata del 50%, superando quota 6mila. Un dato che conferma una tendenza già in atto con epidemie che nel 2025 continuano a dilagare.
Una recrudescenza che non è un episodio isolato, ma si inserisce in un fenomeno più ampio, quello del ritorno di malattie infettive che si pensavano ormai superate, come morbillo e rosolia, che stanno riaffacciandosi in diverse regioni del mondo.
CHE COS’È IL COLERA E COME SI TRASMETTE
Il colera è un’infezione acuta dell’intestino tenue causata dal batterio Vibrio cholerae, presente in diverse varianti sierologiche, ma con due principali responsabili delle epidemie: i sierogruppi O1 e O139. Una volta ingerito attraverso acqua o alimenti contaminati da feci, il batterio raggiunge l’intestino e produce una tossina che altera il normale equilibrio dei liquidi, causando perdite massive di acqua e sali minerali.
La malattia si manifesta con diarrea improvvisa, abbondante e acquosa, spesso descritta come “ad acqua di riso”, accompagnata da vomito e crampi muscolari. Senza trattamento, la disidratazione può diventare così grave da condurre alla morte nel giro di poche ore. Nei casi lievi o asintomatici, invece, l’infezione può passare inosservata, favorendo la diffusione del batterio nella comunità.
Il periodo di incubazione varia da poche ore a cinque giorni. Proprio questa rapidità, insieme alla facilità di trasmissione in aree prive di acqua sicura e servizi igienici, spiega la capacità del colera di trasformarsi in epidemia in tempi molto brevi.
Nonostante i progressi della medicina e della microbiologia, resta una malattia indicativa delle disuguaglianze globali, poiché laddove mancano acqua potabile, igiene e accesso alle cure, il rischio esplode.
Il trattamento si basa principalmente sulla reidratazione orale o endovenosa, mentre gli antibiotici si usano solo nei casi più gravi per ridurre la durata della malattia. Sono disponibili vaccini orali efficaci, ma l’accesso rimane limitato in molti dei Paesi colpiti.
L’EPIDEMIOLOGIA ATTUALE SECONDO L’OMS
Il quadro delineato dall’OMS mostra come nel 2024 il colera abbia interessato 60 Paesi, contro i 45 del 2023, con una concentrazione del 98% dei casi in Africa, Medio Oriente e Asia. Dodici nazioni hanno registrato più di 10mila casi ciascuna e in sette si sono sviluppate grandi epidemie per la prima volta. Il tasso di mortalità in Africa è salito all’1,9% rispetto all’1,4% del 2023, dati che evidenziano la fragilità dei sistemi sanitari e la difficoltà di accesso alle cure di base.
Tra i fattori che alimentano la diffusione ci sono conflitti, sfollamenti, cambiamenti climatici e carenze croniche nelle infrastrutture idriche e igienico-sanitarie.
Nonostante l’introduzione di un nuovo vaccino orale nel 2024, la domanda globale di dosi resta superiore all’offerta, con campagne condotte spesso a dose singola invece che a due.
IL RITORNO DELLE MALATTIE INFETTIVE DIMENTICATE
Il colera è solo la punta dell’iceberg. Il morbillo, che l’OMS aveva dichiarato prossimo all’eliminazione in diverse aree, è tornato a diffondersi anche in Europa, complice il calo delle coperture vaccinali. Analogamente la rosolia e altre malattie virali stanno riemergendo, favorite dalla globalizzazione, dai cambiamenti climatici che ampliano gli habitat dei vettori e da un rallentamento delle campagne vaccinali in alcune regioni.
Un ritorno che evidenzia la fragilità dei sistemi sanitari di fronte a emergenze improvvise e la necessità di investire in prevenzione, sorveglianza epidemiologica e campagne di immunizzazione mirate.
IMPATTO SULLA SALUTE PUBBLICA E SUI PIÙ VULNERABILI
La diffusione del colera e di altre epidemie non riguarda soltanto i Paesi a basso reddito: in un mondo interconnesso il rischio è globale. Le comunità più vulnerabili, prive di accesso ad acqua potabile e cure tempestive, restano le più colpite, ma a essere esposti sono anche i soggetti con malattie croniche o rare, che rischiano complicazioni gravi in caso di infezione. Per questi gruppi, un’epidemia potrebbe tradursi in un aggravamento delle condizioni di salute, interruzione delle cure e isolamento sociale.
Il ritorno del colera e di altre malattie infettive non va sottovalutato. La prevenzione, la diagnosi precoce, la vaccinazione e il rafforzamento dei sistemi sanitari sono strumenti essenziali per proteggere non solo la popolazione generale ma soprattutto le persone più fragili. Le epidemie ci ricordano che nessuna malattia può dirsi davvero sconfitta e che la vigilanza deve restare sempre alta.

Seguici sui Social